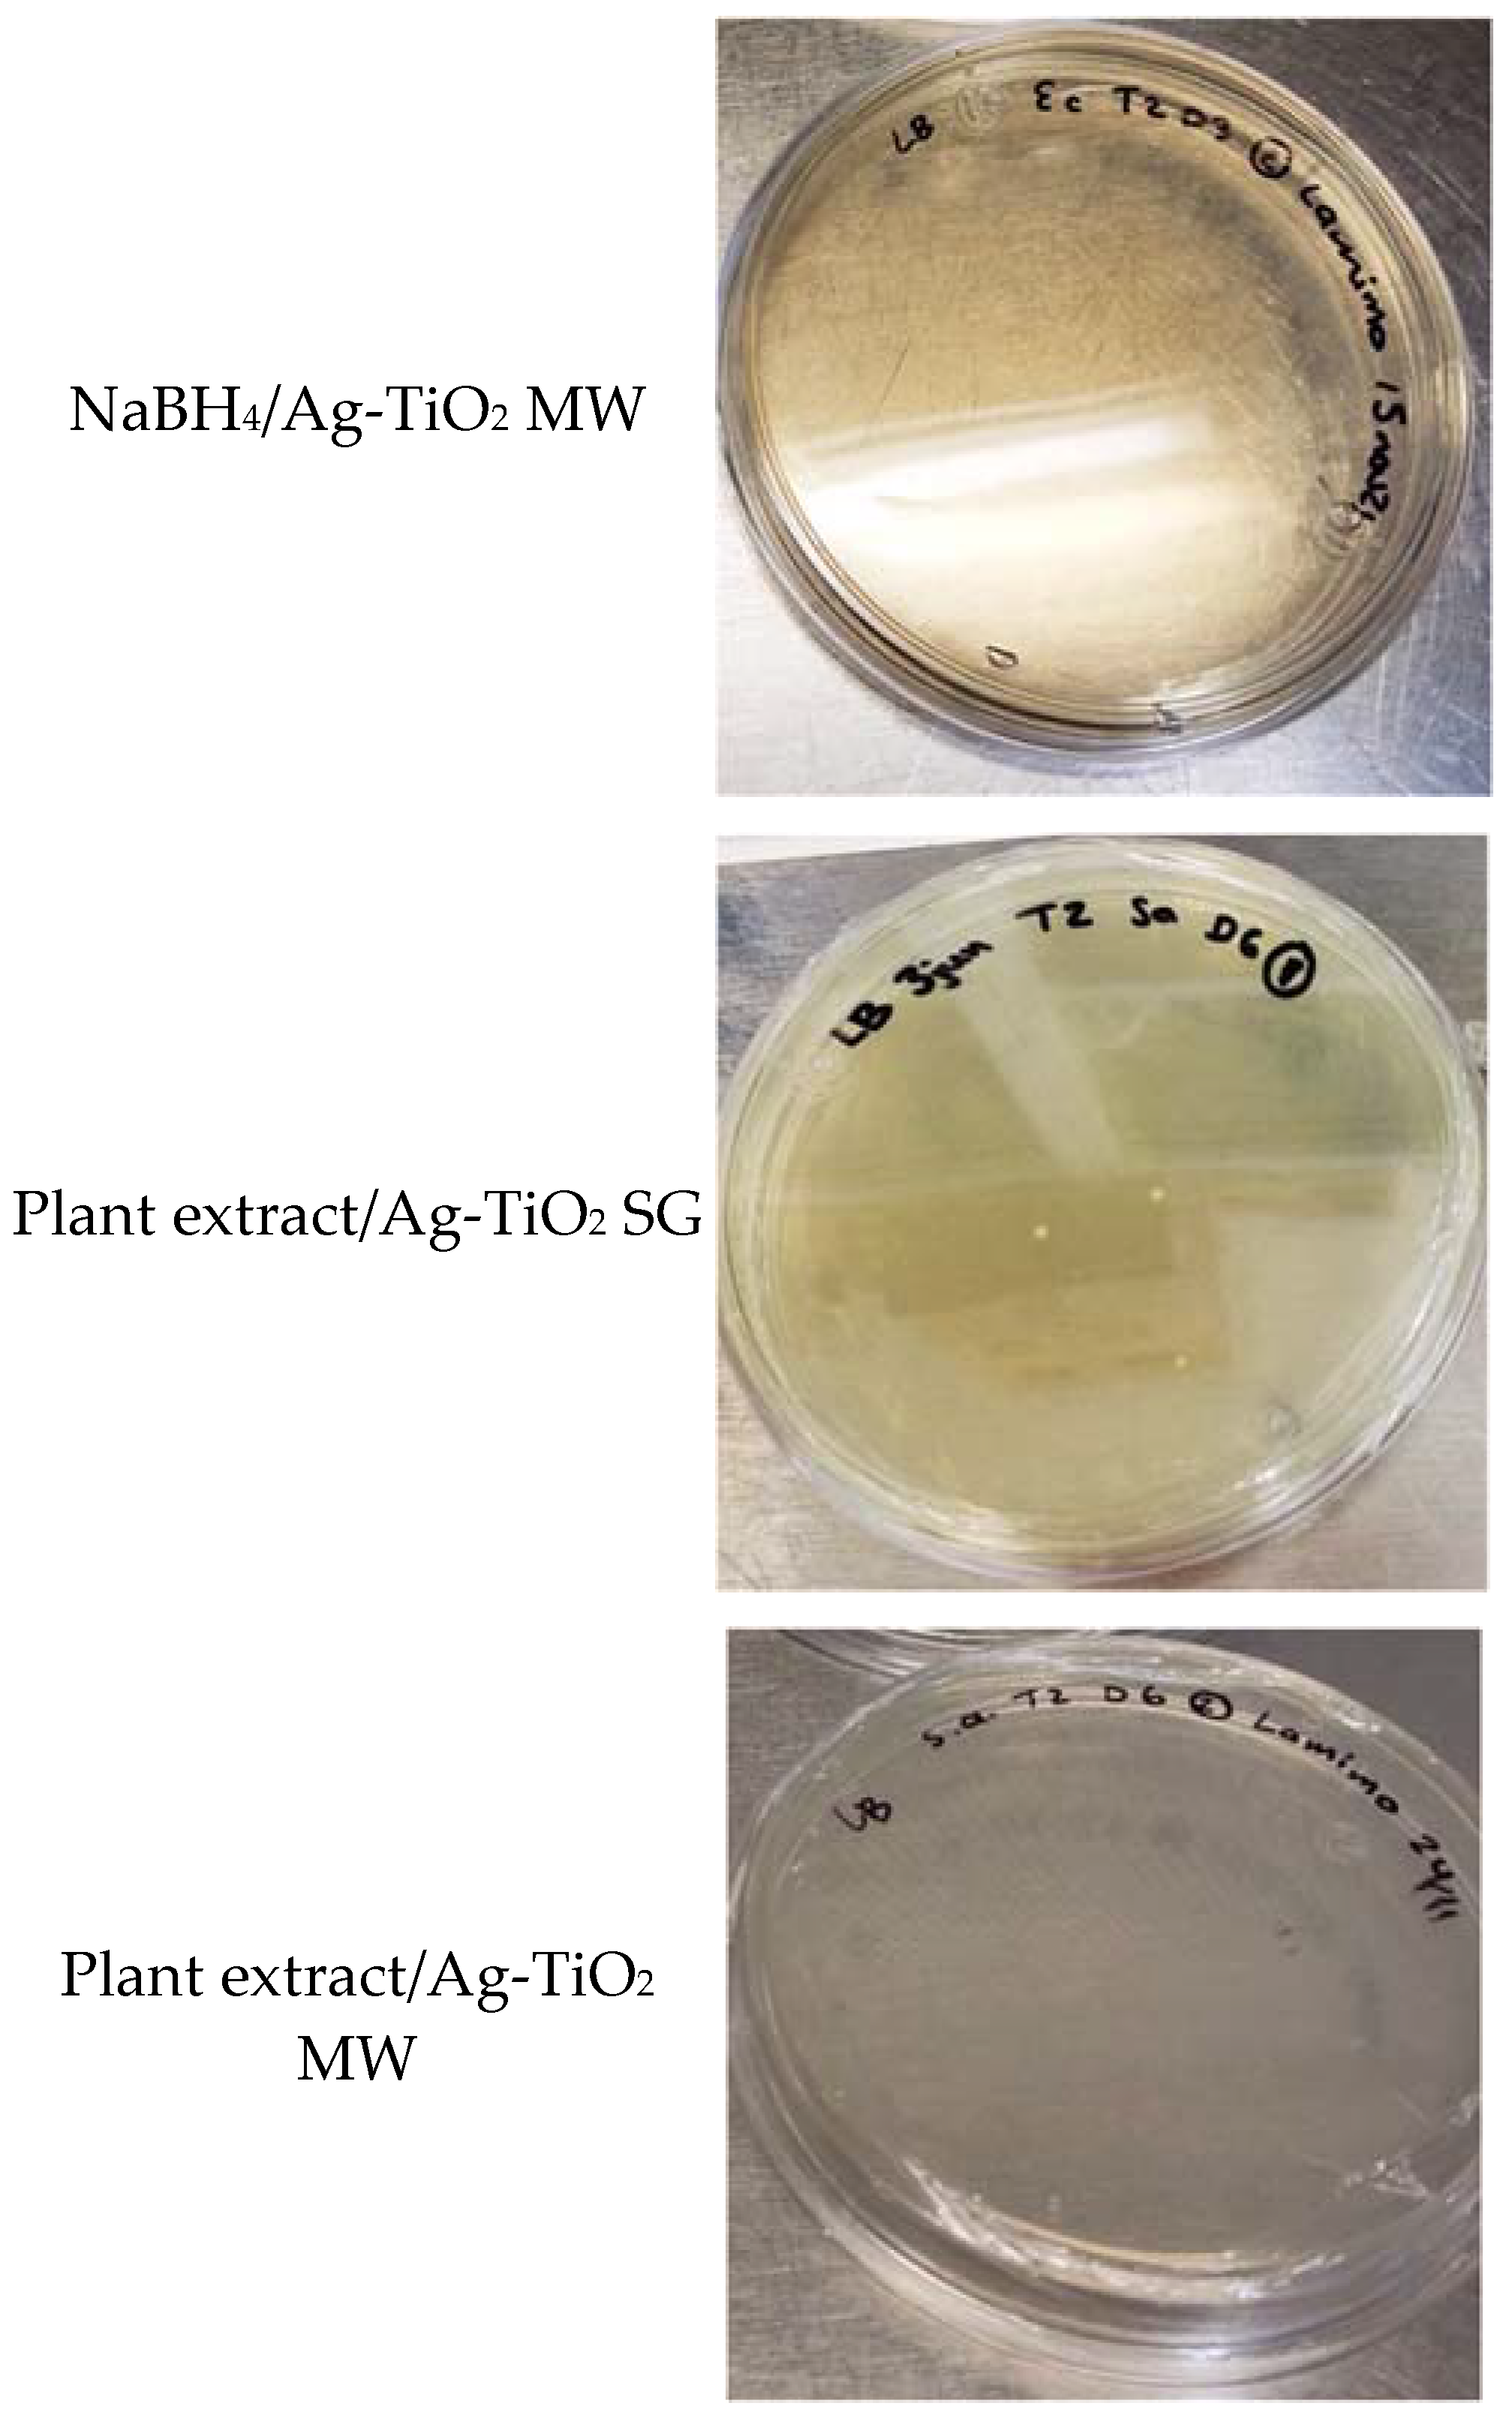
Nanomaterials 12 01944 g011b 550

Green Synthesis via Eucalyptus globulus L. Extract of Ag-TiO2 Catalyst: Antimicrobial Activity Evaluation toward Water Disinfection Process
Abstract
:1. Introduction
2. Materials and Methods
2.1. Eucalyptus globulus L. Extract Preparation and Secondary Metabolite Quantification
2.2. Catalyst’s Synthesis and Characterization
2.3. Antimicrobial Evaluation by Direct Contact
3. Results
3.1. Plant Extract Characterization
3.1.1. UV–Vis and IR Spectroscopies
3.1.2. Secondary Metabolites Evaluation
3.2. Physicochemical Characterization of Ag0, TiO2, and Ag-TiO2 Materials
3.2.1. UV-Visible Spectroscopy
3.2.2. SEM and TEM Characterization
3.2.3. Cristalographic Analysis (XRD and Raman Spectroscopy)
3.2.4. XPS
3.3. Antimicrobial Activity
4. Discussion
5. Conclusions
Author Contributions
Funding
Institutional Review Board Statement
Informed Consent Statement
Data Availability Statement
Acknowledgments
Conflicts of Interest
References
- Kurhade, P.; Kodape, S.; Choudhury, R. Overview on green synthesis of metallic nanoparticles. Chem. Pap. 2021, 75, 5187–5222. [Google Scholar] [CrossRef]
- Bukhari, A.; Ijaz, I.; Gilani, E.; Nazir, A.; Zain, H.; Saeed, R.; Alarfaji, S.S.; Hussain, S.; Aftab, R.; Naseer, Y. Green Synthesis of Metal and Metal Oxide Nanoparticles Using Different Plants’ Parts for Antimicrobial Activity and Anticancer Activity: A Review Article. Coatings 2021, 11, 1374. [Google Scholar] [CrossRef]
- Md Ishak, N.A.I.; Kamarudin, S.K.; Timmiati, S.N. Green synthesis of metal and metal oxide nanoparticles via plant extracts: An overview. Mater. Res. Express 2019, 6, 112004. [Google Scholar] [CrossRef]
- Salgado, P.; Mártire, D.O.; Vidal, G. Eucalyptus extracts-mediated synthesis of metallic and metal oxide nanoparticles: Current status and perspectives. Mater. Res. Express 2019, 6, 082006. [Google Scholar] [CrossRef]
- Balamurugan, M.; Saravanan, S. Green Synthesis of Silver Nanoparticles by using Eucalyptus Globulus Leaf Extract. J. Inst. Eng. Ser. A 2017, 98, 461–467. [Google Scholar] [CrossRef]
- Barzinjy, A.A.; Azeez, H.H. Green synthesis and characterization of zinc oxide nanoparticles using Eucalyptus globulus Labill. leaf extract and zinc nitrate hexahydrate salt. SN Appl. Sci. 2020, 2, 991. [Google Scholar] [CrossRef]
- Mustapha, T.; Misni, N.; Ithnin, N.R.; Daskum, A.M.; Unyah, N.Z. A Review on Plants and Microorganisms Mediated Synthesis of Silver Nanoparticles, Role of Plants Metabolites and Applications. Int. J. Environ. Res. Public Health 2022, 19, 674. [Google Scholar] [CrossRef]
- Huq, M.A.; Ashrafudoulla, M.; Rahman, M.M.; Balusamy, S.R.; Akter, S. Green Synthesis and Potential Antibacterial Applications of Bioactive Silver Nanoparticles: A Review. Polymers 2022, 14, 742. [Google Scholar] [CrossRef]
- Oza, G.; Reyes-Calderón, A.; Mewada, A.; Arriaga, L.G.; Cabrera, G.B.; Luna, D.E.; Iqbal, H.M.N.; Sharon, M.; Sharma, A. Plant-based metal and metal alloy nanoparticle synthesis: A comprehensive mechanistic approach. J. Mater. Sci. 2020, 55, 1309–1330. [Google Scholar] [CrossRef]
- Nagajyothi, P.C.; Prabhakar Vattikuti, S.V.; Devarayapalli, K.C.; Yoo, K.; Shim, J.; Sreekanth, T.V.M. Green synthesis: Photocatalytic degradation of textile dyes using metal and metal oxide nanoparticles-latest trends and advancements. Crit. Rev. Environ. Sci. Technol. 2020, 50, 2617–2723. [Google Scholar] [CrossRef]
- Maťátková, O.; Michailidu, J.; Miškovská, A.; Kolouchová, I.; Masák, J.; Čejková, A. Antimicrobial properties and applications of metal nanoparticles biosynthesized by green methods. Biotechnol. Adv. 2022, 58, 107905. [Google Scholar] [CrossRef]
- Naikoo, G.A.; Mustaqeem, M.; Hassan, I.U.; Awan, T.; Arshad, F.; Salim, H.; Qurashi, A. Bioinspired and green synthesis of nanoparticles from plant extracts with antiviral and antimicrobial properties: A critical review. J. Saudi Chem. Soc. 2021, 25, 101304. [Google Scholar] [CrossRef]
- Salih, T.A.; Hassan, K.T.; Majeed, S.R.; Ibraheem, I.J.; Hassan, O.M.; Obaid, A.S. In vitro scolicidal activity of synthesised silver nanoparticles from aqueous plant extract against Echinococcus granulosus. Biotechnol. Rep. 2020, 28, e00545. [Google Scholar] [CrossRef] [PubMed]
- Sarkar, M.; Denrah, S.; Das, M.; Das, M. Statistical optimization of bio-mediated silver nanoparticles synthesis for use in catalytic degradation of some azo dyes. Chem. Phys. Impact 2021, 3, 100053. [Google Scholar] [CrossRef]
- Magalhães-Ghiotto, G.A.V.; Oliveira, A.M.d.; Natal, J.P.S.; Bergamasco, R.; Gomes, R.G. Green nanoparticles in water treatment: A review of research trends, applications, environmental aspects and large-scale production. Environ. Nanotechnol. Monit. Manag. 2021, 16, 100526. [Google Scholar] [CrossRef]
- Zhang, Y.; Zhao, Y.-G.; Maqbool, F.; Hu, Y. Removal of antibiotics pollutants in wastewater by UV-based advanced oxidation processes: Influence of water matrix components, processes optimization and application: A review. J. Water Process. Eng. 2022, 45, 102496. [Google Scholar] [CrossRef]
- Ge, M.; Hu, Z.; Wei, J.; He, Q.; He, Z. Recent advances in persulfate-assisted TiO2-based photocatalysis for wastewater treatment: Performances, mechanism and perspectives. J. Alloys Compd. 2021, 888, 161625. [Google Scholar] [CrossRef]
- Pasini, S.M.; Valério, A.; Yin, G.; Wang, J.; de Souza, S.M.A.G.U.; Hotza, D.; de Souza, A.A.U. An overview on nanostructured TiO2–containing fibers for photocatalytic degradation of organic pollutants in wastewater treatment. J. Water Process. Eng. 2021, 40, 101827. [Google Scholar] [CrossRef]
- Paumo, H.K.; Dalhatou, S.; Katata-Seru, L.M.; Kamdem, B.P.; Tijani, J.O.; Vishwanathan, V.; Kane, A.; Bahadur, I. TiO2 assisted photocatalysts for degradation of emerging organic pollutants in water and wastewater. J. Mol. Liq. 2021, 331, 115458. [Google Scholar] [CrossRef]
- He, J.; Kumar, A.; Khan, M.; Lo, I.M.C. Critical review of photocatalytic disinfection of bacteria: From noble metals- and carbon nanomaterials-TiO2 composites to challenges of water characteristics and strategic solutions. Sci. Total Environ. 2021, 758, 143953. [Google Scholar] [CrossRef]
- Liu, K.; Chen, J.; Sun, F.; Liu, Y.; Tang, M.; Yang, Y. Historical development and prospect of intimately coupling photocatalysis and biological technology for pollutant treatment in sewage: A review. Sci. Total Environ. 2022, 835, 155482. [Google Scholar] [CrossRef]
- Wang, H.; Li, X.; Zhao, X.; Li, C.; Song, X.; Zhang, P.; Huo, P.; Li, X. A review on heterogeneous photocatalysis for environmental remediation: From semiconductors to modification strategies. Chin. J. Catal. 2022, 43, 178–214. [Google Scholar] [CrossRef]
- Abdelkhalek, A.; El-Latif, M.A.; Ibrahim, H.; Hamad, H.; Showman, M. Controlled synthesis of graphene oxide/silica hybrid nanocomposites for removal of aromatic pollutants in water. Sci. Rep. 2022, 12, 7060. [Google Scholar] [CrossRef] [PubMed]
- Dihom, H.R.; Al-Shaibani, M.M.; Radin Mohamed, R.M.S.; Al-Gheethi, A.A.; Sharma, A.; Khamidun, M.H.B. Photocatalytic degradation of disperse azo dyes in textile wastewater using green zinc oxide nanoparticles synthesized in plant extract: A critical review. J. Water Process. Eng. 2022, 47, 102705. [Google Scholar] [CrossRef]
- González-González, R.B.; Parra-Arroyo, L.; Parra-Saldívar, R.; Ramirez-Mendoza, R.A.; Iqbal, H.M.N. Nanomaterial-based catalysts for the degradation of endocrine-disrupting chemicals—A way forward to environmental remediation. Mater. Lett. 2022, 308, 131217. [Google Scholar] [CrossRef]
- Priya, A.K.; Gnanasekaran, L.; Rajendran, S.; Qin, J.; Vasseghian, Y. Occurrences and removal of pharmaceutical and personal care products from aquatic systems using advanced treatment—A review. Environ. Res. 2022, 204, 112298. [Google Scholar] [CrossRef] [PubMed]
- Somma, S.; Reverchon, E.; Baldino, L. Water Purification of Classical and Emerging Organic Pollutants: An Extensive Review. ChemEngineering 2021, 5, 47. [Google Scholar] [CrossRef]
- Rafieenia, R.; Sulonen, M.; Mahmoud, M.; El-Gohary, F.; Rossa, C.A. Integration of microbial electrochemical systems and photocatalysis for sustainable treatment of organic recalcitrant wastewaters: Main mechanisms, recent advances, and present prospects. Sci. Total Environ. 2022, 824, 153923. [Google Scholar] [CrossRef]
- Lin, Y.-H.; Tseng, W.J. Multifunctional Fe3O4@Ag@TiO2-xNx core-shell composite particles for dye adsorption and visible-light photocatalysis. Ceram. Int. 2022, 48, 13906–13913. [Google Scholar] [CrossRef]
- Sanzone, G.; Zimbone, M.; Cacciato, G.; Ruffino, F.; Carles, R.; Privitera, V.; Grimaldi, M.G. Ag/TiO2 nanocomposite for visible light-driven photocatalysis. Superlattices Microstruct. 2018, 123, 394–402. [Google Scholar] [CrossRef]
- Deekshitha; Shetty, K.V. Solar light active biogenic titanium dioxide embedded silver oxide (AgO/Ag2O@TiO2) nanocomposite structures for dye degradation by photocatalysis. Mater. Sci. Semicond. Process. 2021, 132, 105923. [Google Scholar] [CrossRef]
- He, J.; Zeng, X.; Lan, S.; Lo, I.M.C. Reusable magnetic Ag/Fe, N-TiO2/Fe3O4@SiO2 composite for simultaneous photocatalytic disinfection of E. coli and degradation of bisphenol A in sewage under visible light. Chemosphere 2019, 217, 869–878. [Google Scholar] [CrossRef]
- Wu, M.-C.; Lin, T.-H.; Hsu, K.-H.; Hsu, J.-F. Photo-induced disinfection property and photocatalytic activity based on the synergistic catalytic technique of Ag doped TiO2 nanofibers. Appl. Surf. Sci. 2019, 484, 326–334. [Google Scholar] [CrossRef]
- Vishwanath, R.; Negi, B. Conventional and green methods of synthesis of silver nanoparticles and their antimicrobial properties. Curr. Opin. Green Sustain. Chem. 2021, 4, 100205. [Google Scholar] [CrossRef]
- Szołdra, P.; Frąc, M.; Pichór, W. Effect of sol composition on the properties of TiO2 powders obtained by the sol-gel method. Powder Technol. 2021, 387, 261–269. [Google Scholar] [CrossRef]
- Komaraiah, D.; Radha, E.; Sivakumar, J.; Ramana Reddy, M.V.; Sayanna, R. Photoluminescence and photocatalytic activity of spin coated Ag+ doped anatase TiO2 thin films. Opt. Mater. 2020, 108, 110401. [Google Scholar] [CrossRef]
- Puga, F.; Navío, J.A.; Jaramillo-Páez, C.; Sánchez-Cid, P.; Hidalgo, M.C. Microwave-assisted sol-gel synthesis of TiO2 in the presence of halogenhydric acids. Characterization and photocatalytic activity. J. Photochem. Photobiol. A Chem. 2020, 394, 112457. [Google Scholar] [CrossRef]
- Hernández, R.; Hernández-Reséndiz, J.R.; Martínez-Chávez, A.; Velázquez-Castillo, R.; Escobar-Alarcón, L.; Esquivel, K. X-ray diffraction Rietveld structural analysis of Au–TiO2 powders synthesized by sol–gel route coupled to microwave and sonochemistry. J. Sol-Gel Sci. Technol. 2020, 95, 239–252. [Google Scholar] [CrossRef]
- Bandeira, C.R.P.P.; Dória, A.R.; Cruz Ribeiro, J.Y.; Prado, L.R.; Anjos de Jesus, R.; Carvalho Andrade, H.M.; Souza de Santana Castro, R.; Romanholo Ferreira, L.F.; Egues, S.M.S.; Figueiredo, R.T. Tuning the sound frequency in the audible region during the synthesis of the precursor TiO2: Evaluation of the sound effect on the structure and photoactivity relationship. Mater. Chem. Phys. 2021, 265, 124521. [Google Scholar] [CrossRef]
- Haider, A.J.; Thamir, A.D.; Najim, A.A.; Ali, G.A. Improving Efficiency of TiO2:Ag/Si Solar Cell Prepared by Pulsed Laser Deposition. Plasmonics 2017, 12, 105–115. [Google Scholar] [CrossRef]
- Shah, S.I.; Mahmoud, S.A.; Bendary, S.H.; Aboulgheit, A.K.; Salem, A.A.; Fouad, O.A. Efficient removal of 2-chlorophenol from aqueous solution using TiO2 thin films/alumina disc as photocatalyst by pulsed laser deposition. Appl. Water Sci. 2021, 11, 44. [Google Scholar] [CrossRef]
- Ağırseven, O.; Biswas, P.; Tate, J. Amorphous-to-crystalline transition of thin-film TiO2 precursor films to brookite, anatase, and rutile polymorphs. J. Mater. Res. 2022, 37, 1135–1143. [Google Scholar] [CrossRef]
- Doghmane, H.E.; Touam, T.; Chelouche, A.; Challali, F.; Bordji, B. Investigation of the Influences of Post-Thermal Annealing on Physical Properties of TiO2 Thin Films Deposited by RF Sputtering. Semiconductors 2020, 54, 268–273. [Google Scholar] [CrossRef]
- Mahesh, S.; Narasaiah, B.P.; Balaji, G.L. Fabrication of Titanium Dioxide Nanoparticles Using Sunflower Leaf Extract and Their Applications Towards the Synthesis and Biological Evaluation of Some Novel Phenanthro Imidazole Derivatives. Biointerface Res. Appl. Chem. 2022, 12, 3372–3389. [Google Scholar] [CrossRef]
- Shiva Samhitha, S.; Raghavendra, G.; Quezada, C.; Hima Bindu, P. Green synthesized TiO2 nanoparticles for anticancer applications: Mini review. Mater. Today Proc. 2021, 54, 765–770. [Google Scholar] [CrossRef]
- Palma, T.L.; Vieira, B.; Nunes, J.; Lourenço, J.P.; Monteiro, O.C.; Costa, M.C. Photodegradation of chloramphenicol and paracetamol using PbS/TiO2 nanocomposites produced by green synthesis. J. Iran. Chem. Soc. 2020, 17, 2013–2031. [Google Scholar] [CrossRef]
- Gonçalves, R.A.; Toledo, R.P.; Joshi, N.; Berengue, O.M. Green Synthesis and Applications of ZnO and TiO2 Nanostructures. Molecules 2021, 26, 2236. [Google Scholar] [CrossRef]
- Zhu, X.; Pathakoti, K.; Hwang, H.-M. Chapter 10—Green synthesis of titanium dioxide and zinc oxide nanoparticles and their usage for antimicrobial applications and environmental remediation. In Green Synthesis, Characterization and Applications of Nanoparticles; Shukla, A.K., Iravani, S., Eds.; Elsevier: Amsterdam, Netherlands, 2019; pp. 223–263. [Google Scholar]
- Carson, L.; Bandara, S.; Joseph, M.; Green, T.; Grady, T.; Osuji, G.; Weerasooriya, A.; Ampim, P.; Woldesenbet, S. Green Synthesis of Silver Nanoparticles with Antimicrobial Properties Using Phyla dulcis Plant Extract. Foodborne Pathog. Dis. 2020, 17, 504–511. [Google Scholar] [CrossRef] [PubMed]
- Nabi, G.; Majid, A.; Riaz, A.; Alharbi, T.; Arshad Kamran, M.; Al-Habardi, M. Green synthesis of spherical TiO2 nanoparticles using Citrus Limetta extract: Excellent photocatalytic water decontamination agent for RhB dye. Inorg. Chem. Commun. 2021, 129, 108618. [Google Scholar] [CrossRef]
- Singh, A.; Goyal, V.; Singh, J.; Rawat, M. Structural, morphological, optical and photocatalytic properties of green synthesized TiO2 NPs. Curr. Opin. Green Sustain. Chem. 2020, 3, 100033. [Google Scholar] [CrossRef]
- Rehman, S.; Farooq, R.; Jermy, R.; Mousa Asiri, S.; Ravinayagam, V.; Al Jindan, R.; Alsalem, Z.; Shah, M.A.; Reshi, Z.; Sabit, H.; et al. A Wild Fomes fomentarius for Biomediation of One Pot Synthesis of Titanium Oxide and Silver Nanoparticles for Antibacterial and Anticancer Application. Biomolecules 2020, 10, 622. [Google Scholar] [CrossRef] [PubMed] [Green Version]
- Castillo-Henríquez, L.; Alfaro-Aguilar, K.; Ugalde-Álvarez, J.; Vega-Fernández, L.; Montes de Oca-Vásquez, G.; Vega-Baudrit, J.R. Green Synthesis of Gold and Silver Nanoparticles from Plant Extracts and Their Possible Applications as Antimicrobial Agents in the Agricultural Area. Nanomaterials 2020, 10, 1763. [Google Scholar] [CrossRef] [PubMed]
- Ansari, A.; Siddiqui, V.U.; Rehman, W.U.; Akram, M.K.; Siddiqi, W.A.; Alosaimi, A.M.; Hussein, M.A.; Rafatullah, M. Green Synthesis of TiO2 Nanoparticles Using Acorus calamus Leaf Extract and Evaluating Its Photocatalytic and In Vitro Antimicrobial Activity. Catalysts 2022, 12, 181. [Google Scholar] [CrossRef]
- Flieger, J.; Franus, W.; Panek, R.; Szymańska-Chargot, M.; Flieger, W.; Flieger, M.; Kołodziej, P. Green Synthesis of Silver Nanoparticles Using Natural Extracts with Proven Antioxidant Activity. Molecules 2021, 26, 4986. [Google Scholar] [CrossRef]
- Hashmi, S.S.; Shah, M.; Muhammad, W.; Ahmad, A.; Ullah, M.A.; Nadeem, M.; Abbasi, B.H. Potentials of phyto-fabricated nanoparticles as ecofriendly agents for photocatalytic degradation of toxic dyes and waste water treatment, risk assessment and probable mechanism. J. Indian Chem. Soc. 2021, 98, 100019. [Google Scholar] [CrossRef]
- Alabdallah, N.M.; Hasan, M.M. Plant-based green synthesis of silver nanoparticles and its effective role in abiotic stress tolerance in crop plants. Saudi J. Biol. Sci. 2021, 28, 5631–5639. [Google Scholar] [CrossRef]
- Balaji, S.; Guda, R.; Mandal, B.K.; Kasula, M.; Ubba, E.; Khan, F.-R.N. Green synthesis of nano-titania (TiO2 NPs) utilizing aqueous Eucalyptus globulus leaf extract: Applications in the synthesis of 4H-pyran derivatives. Res. Chem. Intermed. 2021, 47, 3919–3931. [Google Scholar] [CrossRef]
- Hariharan, D.; Thangamuniyandi, P.; Jegatha Christy, A.; Vasantharaja, R.; Selvakumar, P.; Sagadevan, S.; Pugazhendhi, A.; Nehru, L.C. Enhanced photocatalysis and anticancer activity of green hydrothermal synthesized Ag@TiO2 nanoparticles. J. Photochem. Photobiol. B Biol. 2020, 202, 111636. [Google Scholar] [CrossRef]
- Rajkumar, S.; Venkatraman, M.R.; Balraju, P.; Suguna, K.; Pugazhendhi, A. Performance of simple green synthesized Ag incorporated TiO2 nanoparticles based photoanodes by doctor-blade coating as working electrodes for dye sensitized solar cells. Prog. Org. Coat. 2022, 164, 106697. [Google Scholar] [CrossRef]
- Esquivel, K.; Nava, R.; Zamudio-Méndez, A.; González, M.V.; Jaime-Acuña, O.E.; Escobar-Alarcón, L.; Peralta-Hernández, J.M.; Pawelec, B.; Fierro, J.L.G. Microwave-assisted synthesis of (S)Fe/TiO2 systems: Effects of synthesis conditions and dopant concentration on photoactivity. Appl. Catal. B 2013, 140–141, 213–224. [Google Scholar] [CrossRef]
- Rodríguez-Méndez, A.; Guzmán, C.; Elizalde-Peña, E.A.; Escobar-Alarcón, L.; Vega, M.; Rivera, J.A.; Esquivel, K. Effluent Disinfection of Real Wastewater by Ag-TiO2 Nanoparticles Photocatalysis. J. Nanosci. Nanotechnol. 2017, 17, 711–719. [Google Scholar] [CrossRef]
- Hernández, R.; Olvera-Rodríguez, I.; Guzmán, C.; Medel, A.; Escobar-Alarcón, L.; Brillas, E.; Sirés, I.; Esquivel, K. Microwave-assisted sol-gel synthesis of an Au-TiO2 photoanode for the advanced oxidation of paracetamol as model pharmaceutical pollutant. Electrochem. Commun. 2018, 96, 42–46. [Google Scholar] [CrossRef]
- Landi, S.; Segundo, I.R.; Freitas, E.; Vasilevskiy, M.; Carneiro, J.; Tavares, C.J. Use and misuse of the Kubelka-Munk function to obtain the band gap energy from diffuse reflectance measurements. Solid State Commun. 2022, 341, 114573. [Google Scholar] [CrossRef]
- Dehghani, A.; Bahlakeh, G.; Ramezanzadeh, B. Green Eucalyptus leaf extract: A potent source of bio-active corrosion inhibitors for mild steel. Bioelectrochemistry 2019, 130, 107339. [Google Scholar] [CrossRef]
- de Silva, M.G.; de Barros, M.A.S.D.; de Almeida, R.T.R.; Pilau, E.J.; Pinto, E.; Soares, G.; Santos, J.G. Cleaner production of antimicrobial and anti-UV cotton materials through dyeing with eucalyptus leaves extract. J. Clean. Prod. 2018, 199, 807–816. [Google Scholar] [CrossRef]
- Pourmortazavi, S.M.; Taghdiri, M.; Makari, V.; Rahimi-Nasrabadi, M. Procedure optimization for green synthesis of silver nanoparticles by aqueous extract of Eucalyptus oleosa. Spectrochim. Acta A 2015, 136, 1249–1254. [Google Scholar] [CrossRef]
- Mo, Y.; Tang, Y.; Wang, S.; Lin, J.; Zhang, H.; Luo, D. Green synthesis of silver nanoparticles using eucalyptus leaf extract. Mater. Lett. 2015, 144, 165–167. [Google Scholar] [CrossRef]
- Obeizi, Z.; Benbouzid, H.; Ouchenane, S.; Yılmaz, D.; Culha, M.; Bououdina, M. Biosynthesis of Zinc oxide nanoparticles from essential oil of Eucalyptus globulus with antimicrobial and anti-biofilm activities. Mater. Today Commun. 2020, 25, 101553. [Google Scholar] [CrossRef]
- Alhalili, Z. Green synthesis of copper oxide nanoparticles CuO NPs from Eucalyptus Globoulus leaf extract: Adsorption and design of experiments. Arab. J. Chem. 2022, 15, 103739. [Google Scholar] [CrossRef]
- Masood, K.; Yasmin, H.; Batool, S.; Ilyas, N.; Nosheen, A.; Naz, R.; Khan, N.; Nadeem Hassan, M.; Aldhahrani, A.; Althobaiti, F. A strategy for mitigating avian colibacillosis disease using plant growth promoting rhizobacteria and green synthesized zinc oxide nanoparticles. Saudi J. Biol. Sci. 2021, 28, 4957–4968. [Google Scholar] [CrossRef]
- Palma, A.; Díaz, M.J.; Ruiz-Montoya, M.; Morales, E.; Giráldez, I. Ultrasound extraction optimization for bioactive molecules from Eucalyptus globulus leaves through antioxidant activity. Ultrason. Sonochem. 2021, 76, 105654. [Google Scholar] [CrossRef]
- Gullón, B.; Gullón, P.; Lú-Chau, T.A.; Moreira, M.T.; Lema, J.M.; Eibes, G. Optimization of solvent extraction of antioxidants from Eucalyptus globulus leaves by response surface methodology: Characterization and assessment of their bioactive properties. Ind. Crops Prod. 2017, 108, 649–659. [Google Scholar] [CrossRef]
- Rodrigues, V.H.; de Melo, M.M.R.; Portugal, I.; Silva, C.M. Extraction of Eucalyptus leaves using solvents of distinct polarity. Cluster analysis and extracts characterization. J. Supercrit. Fluids 2018, 135, 263–274. [Google Scholar] [CrossRef]
- Ixchel, P.-C.; Ramón, G.G.-G.; Ana, A.F.-P.; Rosalía, R.-C.; Iza, F.P.-R.; Rosalía, V.O.-V.; Alejandra Rojas, M.; Francisco, L.-V.; Erik, G.T.-P. Phenolic compounds and antioxidant activity of methanolic extracts from leaves and flowers of chilcuague. Bot. Sci. 2020, 99, 149–160. [Google Scholar] [CrossRef]
- Do, Q.D.; Angkawijaya, A.E.; Tran-Nguyen, P.L.; Huynh, L.H.; Soetaredjo, F.E.; Ismadji, S.; Ju, Y.-H. Effect of extraction solvent on total phenol content, total flavonoid content, and antioxidant activity of Limnophila aromatica. J. Food Drug Anal. 2014, 22, 296–302. [Google Scholar] [CrossRef] [Green Version]
- Ying, S.; Guan, Z.; Ofoegbu, P.C.; Clubb, P.; Rico, C.; He, F.; Hong, J. Green synthesis of nanoparticles: Current developments and limitations. Environ. Technol. Innov. 2022, 26, 102336. [Google Scholar] [CrossRef]
- Munir, H.; Mumtaz, A.; Rashid, R.; Najeeb, J.; Zubair, M.T.; Munir, S.; Bilal, M.; Cheng, H. Eucalyptus camaldulensis gum as a green matrix to fabrication of zinc and silver nanoparticles: Characterization and novel prospects as antimicrobial and dye-degrading agents. J. Mater. Res. Technol. 2020, 9, 15513–15524. [Google Scholar] [CrossRef]
- Gullón, B.; Muñiz-Mouro, A.; Lú-Chau, T.A.; Moreira, M.T.; Lema, J.M.; Eibes, G. Green approaches for the extraction of antioxidants from eucalyptus leaves. Ind. Crops Prod. 2019, 138, 111473. [Google Scholar] [CrossRef]
- Garcia, M.A. Surface plasmons in metallic nanoparticles: Fundamentals and applications. J. Phys. D Appl. Phys. 2011, 44, 283001. [Google Scholar] [CrossRef]
- Al-Otibi, F.; Perveen, K.; Al-Saif, N.A.; Alharbi, R.I.; Bokhari, N.A.; Albasher, G.; Al-Otaibi, R.M.; Al-Mosa, M.A. Biosynthesis of silver nanoparticles using Malva parviflora and their antifungal activity. Saudi J. Biol. Sci. 2021, 28, 2229–2235. [Google Scholar] [CrossRef] [PubMed]
- Irshad, M.A.; Nawaz, R.; Zia ur Rehman, M.; Imran, M.; Ahmad, J.; Ahmad, S.; Inam, A.; Razzaq, A.; Rizwan, M.; Ali, S. Synthesis and characterization of titanium dioxide nanoparticles by chemical and green methods and their antifungal activities against wheat rust. Chemosphere 2020, 258, 127352. [Google Scholar] [CrossRef]
- Hernández, R.; Hernández-Reséndiz, J.R.; Cruz-Ramírez, M.; Velázquez-Castillo, R.; Escobar-Alarcón, L.; Ortiz-Frade, L.; Esquivel, K. Au-TiO2 Synthesized by a Microwave- and Sonochemistry-Assisted Sol-Gel Method: Characterization and Application as Photocatalyst. Catalysts 2020, 10, 1052. [Google Scholar] [CrossRef]
- Mote, V.D.; Purushotham, Y.; Dole, B.N. Williamson-Hall analysis in estimation of lattice strain in nanometer-sized ZnO particles. J. Theor. Appl. Phys. 2012, 6, 6. [Google Scholar] [CrossRef] [Green Version]
- Martínez-Chávez, L.A.; Rivera-Muñoz, E.M.; Velázquez-Castillo, R.R.; Escobar-Alarcón, L.; Esquivel, K. Au-Ag/TiO2 Thin Films Preparation by Laser Ablation and Sputtering Plasmas for Its Potential Use as Photoanodes in Electrochemical Advanced Oxidation Processes (EAOP). Catalysts 2021, 11, 1406. [Google Scholar] [CrossRef]
- Abad, J.; Böhme, O.; Román, E. Dissociative adsorption of NO on TiO2(110) argon ion bombarded surfaces. Surf. Sci. 2004, 549, 134–142. [Google Scholar] [CrossRef]
- Mccafferty, E.; Wightman, J.P. Determination of the concentration of surface hydroxyl groups on metal oxide films by a quantitative XPS method. Surf. Interface Anal. 1998, 26, 549–564. [Google Scholar] [CrossRef]
- Ferraria, A.M.; Carapeto, A.P.; Botelho do Rego, A.M. X-ray photoelectron spectroscopy: Silver salts revisited. Vacuum 2012, 86, 1988–1991. [Google Scholar] [CrossRef]
- Hassanien, A.S.; Khatoon, U.T. Synthesis and characterization of stable silver nanoparticles, Ag-NPs: Discussion on the applications of Ag-NPs as antimicrobial agents. Phys. B Condens. 2019, 554, 21–30. [Google Scholar] [CrossRef]
- Shivakumar, M.; Nagashree, K.L.; Yallappa, S.; Manjappa, S.; Manjunath, K.S.; Dharmaprakash, M.S. Biosynthesis of silver nanoparticles using pre-hydrolysis liquor of Eucalyptus wood and its effective antimicrobial activity. Enzym. Microb. Technol. 2017, 97, 55–62. [Google Scholar] [CrossRef]
- Farjadian, F.; Akbarizadeh, A.R.; Tayebi, L. Synthesis of novel reducing agent for formation of metronidazole-capped silver nanoparticle and evaluating antibacterial efficiency in gram-positive and gram-negative bacteria. Heliyon 2020, 6, e04747. [Google Scholar] [CrossRef]
- Roy, J. The synthesis and applications of TiO2 nanoparticles derived from phytochemical sources. J. Ind. Eng. Chem. 2022, 106, 1–19. [Google Scholar] [CrossRef]
- Makarov, V.V.; Love, A.J.; Sinitsyna, O.V.; Makarova, S.S.; Yaminsky, I.V.; Taliansky, M.E.; Kalinina, N.O. “Green” nanotechnologies: Synthesis of metal nanoparticles using plants. Acta Nat. 2014, 6, 35–44. [Google Scholar] [CrossRef] [Green Version]
- Balčiūnaitienė, A.; Liaudanskas, M.; Puzerytė, V.; Viškelis, J.; Janulis, V.; Viškelis, P.; Griškonis, E.; Jankauskaitė, V. Eucalyptus globulus and Salvia officinalis Extracts Mediated Green Synthesis of Silver Nanoparticles and Their Application as an Antioxidant and Antimicrobial Agent. Plants 2022, 11, 1085. [Google Scholar] [CrossRef]
- Ali, K.; Ahmed, B.; Dwivedi, S.; Saquib, Q.; Al-Khedhairy, A.A.; Musarrat, J. Microwave Accelerated Green Synthesis of Stable Silver Nanoparticles with Eucalyptus globulus Leaf Extract and Their Antibacterial and Antibiofilm Activity on Clinical Isolates. PLoS ONE 2015, 10, e0131178. [Google Scholar] [CrossRef] [PubMed]
- Al-Shabib, N.A.; Husain, F.M.; Qais, F.A.; Ahmad, N.; Khan, A.; Alyousef, A.A.; Arshad, M.; Noor, S.; Khan, J.M.; Alam, P.; et al. Phyto-Mediated Synthesis of Porous Titanium Dioxide Nanoparticles From Withania somnifera Root Extract: Broad-Spectrum Attenuation of Biofilm and Cytotoxic Properties Against HepG2 Cell Lines. Front. Microbiol. 2020, 11. [Google Scholar] [CrossRef] [PubMed]
- Shumbula, N.P.; Nkabinde, S.S.; Ndala, Z.B.; Mpelane, S.; Shumbula, M.P.; Mdluli, P.S.; Njengele-Tetyana, Z.; Tetyana, P.; Hlatshwayo, T.; Mlambo, M.; et al. Evaluating the antimicrobial activity and cytotoxicity of polydopamine capped silver and silver/polydopamine core-shell nanocomposites. Arab. J. Chem. 2022, 15, 103798. [Google Scholar] [CrossRef]
- Dakal, T.C.; Kumar, A.; Majumdar, R.S.; Yadav, V. Mechanistic Basis of Antimicrobial Actions of Silver Nanoparticles. Front. Microbiol. 2016, 7, 1831. [Google Scholar] [CrossRef] [Green Version]

| Control (μL) | Treatment (μL) | |
|---|---|---|
| LB medium | 225 | 75 |
| Bacteria | 225 | 225 |
| Material | 0 | 150 |
| Total volume | 450 | 450 |
| Solvent | Total Phenols Content (GAE mg/sample g) 1 | Flavonoids Content (RE mg/sample g) 2 | Antioxidant Activity (DPPH) (% Inhibition) | Antioxidant Activity (ABTS) (% Inhibition) |
|---|---|---|---|---|
| EtOH | 58 ± 1 A | 172 ± 12 C | 86.63 ± 0.02 B | 98.690 ± 0.002 A |
| MeOH | 46 ± 7 AB | 299 ± 27 A | 82.31 ± 0.02 C | 99.830 ± 0.001 A |
| EtOH/H2O | 54 ± 15 A | 217 ± 11 B | 94.18 ± 0.01 A | 76.60 ± 0.01 B |
| MeOH/H2O | 45 ± 2 B | 161 ± 15 C | 94.80 ± 0.01 A | 98.990 ± 0.002 A |
| Material | Debye–Scherrer (nm) | Williamson–Hall (nm) | ||
|---|---|---|---|---|
| SG | MW | SG | MW | |
| TiO2 [38,83] | 20.0 | 12.3 | --- | 9.5 |
| NaBH4/Ag-TiO2 | 8.3 | 7.6 | 7.8 | 6.4 |
| Plant extract/Ag-TiO2 | 7.9 | 7.4 | 6.5 | 5.9 |
| Material | Bandgap (eV) | |
|---|---|---|
| SG | MW | |
| TiO2 [61] | 3.2 | 3.1 |
| NaBH4/Ag-TiO2 | 3.2 | 3.1 |
| Plant extract/Ag-TiO2 | 3.2 | 3.1 |
| Material | Inhibition % | |
|---|---|---|
| Staphylococcus aureus (Gram+) | Escherichia coli (Gram−) | |
| NaBH4/Ag NPs | 85 ± 8 | Total |
| Plant extract/Ag NPs | Total | Total |
| TiO2 SG | Undetermined | 30 ± 7 |
| TiO2 MW | 66 ± 4 | 17 ± 7 |
| NaBH4/Ag-TiO2 SG | 99.82 ± 0.01 | Total |
| NaBH4/Ag-TiO2 MW | Total | Total |
| Plant extract/Ag-TiO2 SG | 99.1 ± 0.6 | 96 ± 3 |
| Plant extract/Ag-TiO2 MW | Total | Total |
Publisher’s Note: MDPI stays neutral with regard to jurisdictional claims in published maps and institutional affiliations. |
© 2022 by the authors. Licensee MDPI, Basel, Switzerland. This article is an open access article distributed under the terms and conditions of the Creative Commons Attribution (CC BY) license (https://creativecommons.org/licenses/by/4.0/).
Share and Cite
Torres-Limiñana, J.; Feregrino-Pérez, A.A.; Vega-González, M.; Escobar-Alarcón, L.; Cervantes-Chávez, J.A.; Esquivel, K. Green Synthesis via Eucalyptus globulus L. Extract of Ag-TiO2 Catalyst: Antimicrobial Activity Evaluation toward Water Disinfection Process. Nanomaterials 2022, 12, 1944. https://doi.org/10.3390/nano12111944
Torres-Limiñana J, Feregrino-Pérez AA, Vega-González M, Escobar-Alarcón L, Cervantes-Chávez JA, Esquivel K. Green Synthesis via Eucalyptus globulus L. Extract of Ag-TiO2 Catalyst: Antimicrobial Activity Evaluation toward Water Disinfection Process. Nanomaterials. 2022; 12(11):1944. https://doi.org/10.3390/nano12111944
Chicago/Turabian StyleTorres-Limiñana, Jacqueline, Ana A. Feregrino-Pérez, Marina Vega-González, Luis Escobar-Alarcón, José Antonio Cervantes-Chávez, and Karen Esquivel. 2022. "Green Synthesis via Eucalyptus globulus L. Extract of Ag-TiO2 Catalyst: Antimicrobial Activity Evaluation toward Water Disinfection Process" Nanomaterials 12, no. 11: 1944. https://doi.org/10.3390/nano12111944
APA StyleTorres-Limiñana, J., Feregrino-Pérez, A. A., Vega-González, M., Escobar-Alarcón, L., Cervantes-Chávez, J. A., & Esquivel, K. (2022). Green Synthesis via Eucalyptus globulus L. Extract of Ag-TiO2 Catalyst: Antimicrobial Activity Evaluation toward Water Disinfection Process. Nanomaterials, 12(11), 1944. https://doi.org/10.3390/nano12111944

